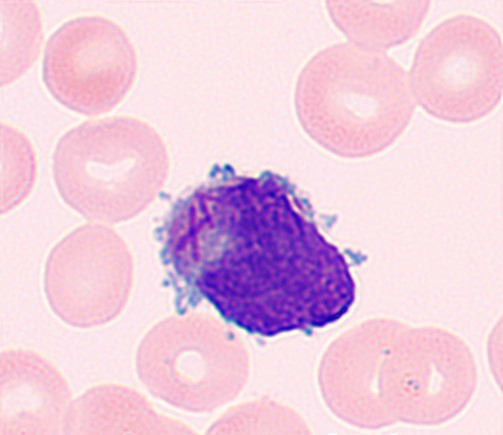
异常早幼粒细胞 异常早幼粒细胞

镜下辨“真凶”,检验医学科前哨预警,助力患者逆转生命
资料来源:
发布者:甘丽姝
时间:2026年04月07日 09:28
近日,我院检验医学科在一例复杂肿瘤患者的常规检查中,凭借扎实的细胞形态学功底与高度的临床警觉性,快速捕捉到急性白血病的致命线索,助力临床多学科团队快速确诊、抢抓黄金救治窗口。这一典型案例,生动彰显了检验医学在危重疾病诊疗中的核心价值。
见微知著,常规检验揪出致命隐患
44岁的李女士(化名)既往有乳腺癌、甲状腺癌手术史,因左乳浸润性导管癌术后化疗后乏力、纳差1月余收入我院外二科(胸外乳腺科)。入院血常规提示红细胞、血红蛋白下降,血小板显著降低,存在中度贫血及高危出血倾向。
在常规复查并进行外周血涂片形态学复核时,检验医学科血液组团队细致甄别,发现血涂片中存在异常细胞,高度符合异常早幼粒细胞形态特征。结合患者肿瘤化疗史及重度血小板减少的表现,检验人员即刻高度警觉,这可能是急性早幼粒细胞白血病(APL,AML-M3)的信号。
异常早幼粒细胞
该病症属于急危重症血液病,起病迅猛、出血风险极高,若延误诊疗极易诱发脏器大出血,危及生命。科室第一时间按危急值管理流程快速上报临床,提示尽快完善骨髓检测、建议血液科会诊,并及时与血液科主任李宏良沟通患者情况。

骨髓涂片
高效协同,多学科联动实现精准诊断
接到危急值预警后,胸外乳腺科高度重视,即刻启动多学科联动诊疗模式,各科室高效联动、闭环处置:
1.通绿色通道,加急专项检测
血液科迅速完成骨髓穿刺取样,检验医学科对危急重症标本试行优先检测,加急开展骨髓形态学分析。结果显示:骨髓增生极度活跃,异常早幼粒细胞占比高达89.5%,初步佐证APL可疑诊断。

流式细胞术免疫分型检测报告
2.依托MICM体系,完成规范分型确诊
为实现标准化、精准诊断,我院联合第三方权威检测平台,完善MICM整合分型检测(形态学、免疫学、细胞遗传学、分子生物学)。最终检查结果符合WHO 2022年第5版造血和淋巴组织肿瘤分类中APL的诊断标准,确诊明确。

APL融合基因检测报告

骨髓细胞染色体核型分析报告
3.组建MDT团队,制定个性化救治方案
血液科、胸外乳腺科、检验医学科迅速组建MDT诊疗团队,由血液科制定ATRA+砷剂规范化靶向治疗方案,同步实施止血、脏器保护等对症支持治疗,快速阻断致命性凝血障碍,及时稳定患者生命体征。目前,患者已顺利开展规范诱导缓解治疗,血小板指标稳步回升。
坚守初心,当好临床诊疗可靠“幕后鹰眼”
急性早幼粒细胞白血病早期以严重出血为首要致死原因,死亡风险远高于其它类型急性髓系白血病,早识别、早预警、早干预是降低早期病死率的关键。
该病目前靶向治疗成熟、临床治愈率高,但李女士叠加双癌术后、化疗后骨髓抑制等干扰因素,极易混淆诊断、掩盖原发病。检验医学科血液专业组团队未局限于“化疗后骨髓抑制”的常规判断,凭借扎实的形态学功底深挖病因,精准甄别隐匿重症,充分展现了检验人见微知著的专业素养与守护生命的责任担当。
“检验人员不只是数据的报告者,更是临床诊疗的导航仪与风向标。”检验医学科主任苏荣表示,镜下每一处细微的细胞改变、每一项异常的指标波动,都是守护生命的关键线索。
本次成功救治,既是院内多学科高效协作的成果,也是检验医学科团队专业技术、质控管理与职业担当的集中体现。方寸镜台担使命,精准检验护安康。检验医学科将继续坚守一线前哨,以专业严谨筑牢临床诊疗安全防线,为医院高质量发展和人民群众健康保驾护航。
作者:蔡惠兴